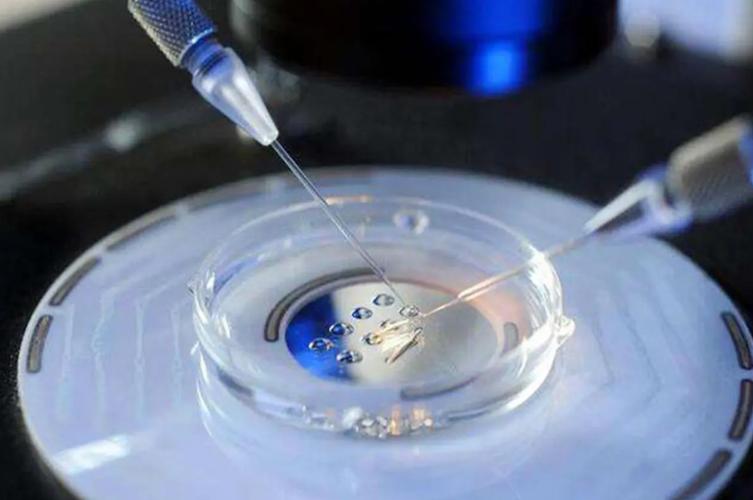
试管代怀多次成功【多次成功的试管代怀奇迹】

试管代怀孕是一种辅助生殖技术,它为那些无法自然怀孕的夫妇提供了一种希望。有时候,一次试管代怀可能并不成功,但多次尝试却能带来奇迹般的成功。本文将介绍多次成功的试管代怀奇迹。
1. 多次成功的试管代怀是可能的
多次成功的试管代怀并不是不可能的。在一些情况下,第一次尝试可能并不成功,但随着医疗技术的不断进步和治疗方案的不断改进,多次尝试能够增加成功的机会。一些夫妇经过多次尝试后成功怀孕,这给了他们新生的希望和幸福。
2. 成功的案例鼓舞人心
有许多成功的案例可以鼓舞那些正在进行试管代怀的夫妇。他们的故事了多次尝试的价值,展现了坚持不懈和信念的力量。这些成功的案例不仅给予了患者信心,也为医生和医疗团队带来了成就感和动力。
3. 多次尝试需要综合考虑
虽然多次尝试能够增加成功的机会,但也需要综合考虑。夫妇们需要在医生的指导下,根据自身的情况和医疗建议,决定是否进行多次尝试。医生会根据患者的身体状况、医疗历史和实验室检查结果等因素,制定合适的治疗方案,帮助夫妇们做出明智的决定。
4. 心理状况也很重要
在进行多次尝试时,夫妇们的心理状况也非常重要。他们可能会经历情绪波动、焦虑和压力,因此需要寻求心理支持和帮助。心理健康专家和心理医生可以帮助他们应对情绪问题,保持积极的心态,增加成功的机会。
问:多次尝试是否会增加风险?
答:多次尝试可能会增加一些风险,如荷尔蒙治疗的副作用、手术风险等。在进行多次尝试时,夫妇们需要充分了解治疗方案的风险和可能的副作用,做好心理和身体的准备。
问:多次尝试的成功率如何?
答:多次尝试的成功率因人而异,取决于夫妇的身体状况、医疗历史和治疗方案。在医生的指导下,选择合适的治疗方案和适当的时机,可以增加成功的机会。
问:多次尝试是否值得?
答:对于那些渴望生育的夫妇来说,多次尝试是值得的。虽然过程可能会充满挑战和困难,但当他们最终迎来健康的宝宝时,一切都是值得的。






